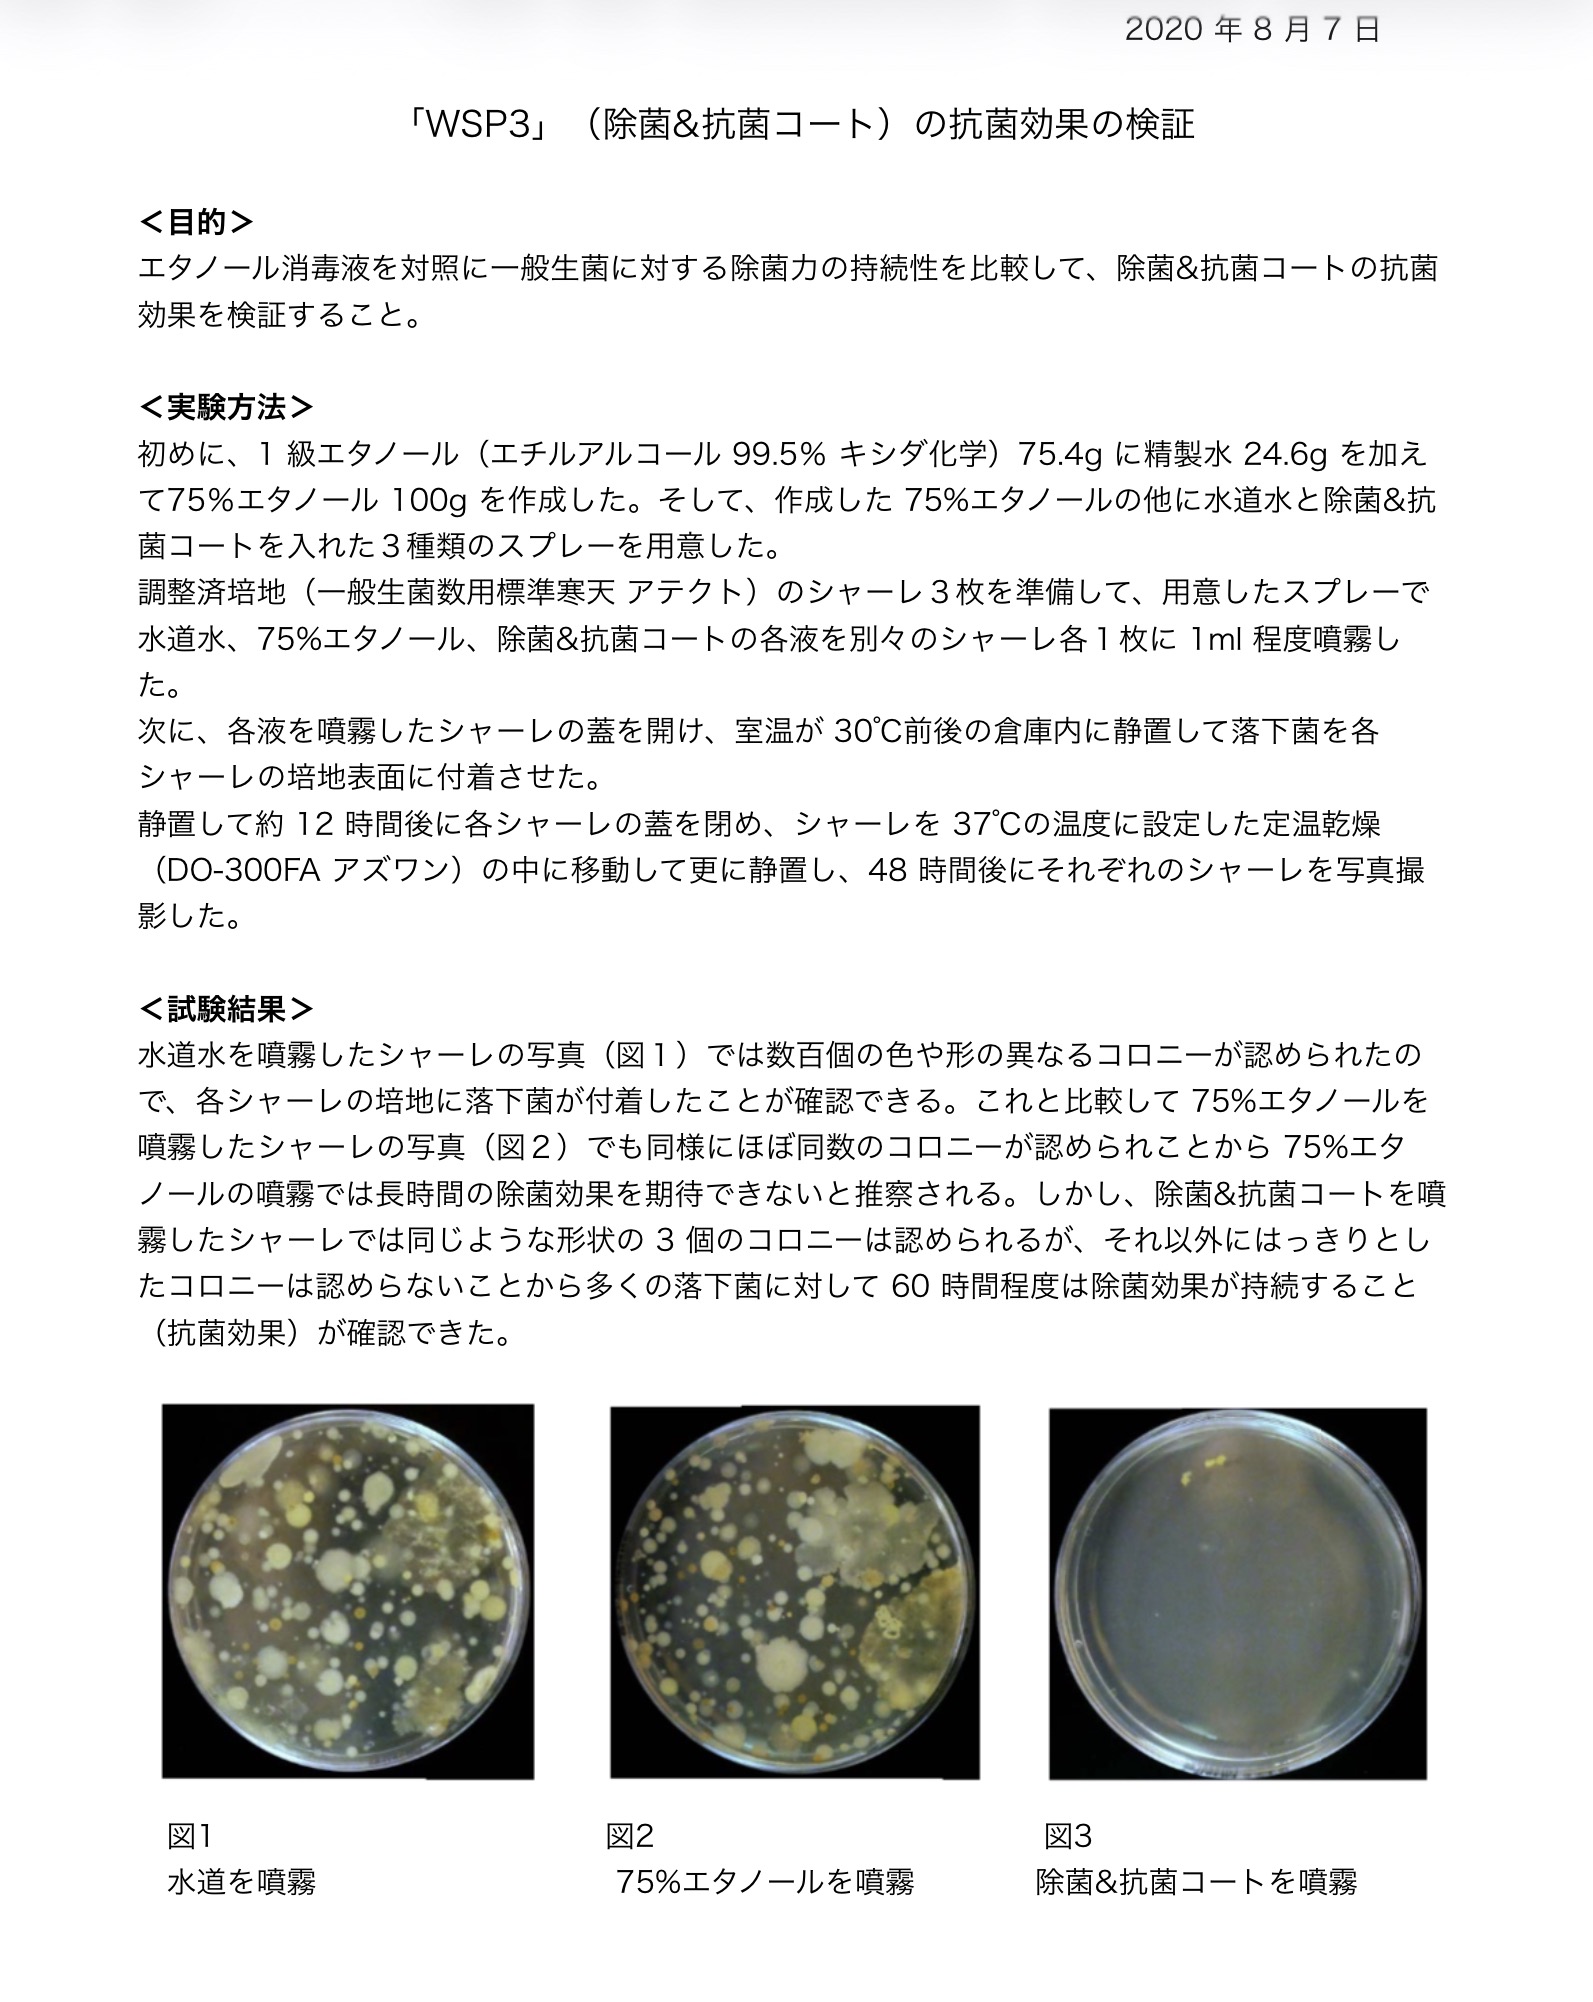
抗菌効果の検証実験

Current Issues
専門業者に依頼してもすぐに再発。終わりのない清掃費用が、毎月の利益を容赦なく削り続けている。
年々厳格化する監査基準。万が一の製品汚染は、致命的な信用失墜と甚大な回収コストに直結する。
防カビ施工のための長時間乾燥は、稼働ライン停止という大損失を招く。また、塩素系薬剤による設備腐食も恐ろしい。
空気中に浮遊するカビ胞子は、健康を脅かす要因に。また、強い刺激臭の薬剤による作業負担も大きな悩みの種となっている。

現場の皆様は、日々徹底した衛生管理に尽力されているはずです。
それでも再発してしまうのは、従来の「漂白剤」や「表面的な清掃」に限界があるからです。
建材の奥深くに根を張った「菌糸」や、強固な「菌核」まで成分が届いていないため、表面上は綺麗に見えても、カビはすぐに息を吹き返してしまうのです。
必要なのは、終わりのない気合と根性の清掃ではなく、
カビの生態と建材の構造に基づいた「科学的な根本解決」です。
Proof of Quality
様々な現場環境で、素材を傷めずにカビを根本除去します。
 BEFORE
BEFORE
 AFTER
AFTER
 BEFORE
BEFORE
 AFTER
AFTER
 BEFORE
BEFORE
 AFTER
AFTER
 WORK IN PROGRESS
WORK IN PROGRESS
 AFTER
AFTER
Sustainability

01. BEFORE
施工前(2022.2.5)

02. AFTER
施工直後(2022.2.5)

03. 1 YEAR LATER
1年後(2023.1.14)
周囲の未施工部分にはカビが繁殖していますが、WSP施工箇所は
1年経過後も美観を維持しています。
Mechanism
WSPがカビを根本から絶てる理由は、建材の構造に基づいたアプローチにあります。
建材の表面を削る物理的除去から、建材内部をリセットする化学的「根本分解」へ。
現状(従来工法)

表面を除去しても奥に「菌糸」が残り再発。
WSP 1 (浸透)

菌糸の最深部まで浸透し殻を軟化。
WSP 2 (分解)

深部で中和反応。「菌核」を破壊し漂白。
WSP 3 (保護)

菌の細胞膜を破壊し、再繁殖を不活性化。
Objective Evidence
食品工場や商業施設で求められる厳しい基準をクリアする根拠があります。
75%エタノールとの除菌力・持続性の比較実験。エタノールでは長時間の効果が期待できないのに対し、WSPの抗菌コート(WSP3)は、多くの落下菌に対して60時間も除菌効果を持続することが実証されています。
専門スタッフが訪問し、一部エリアで実際にWSPを施工。圧倒的な効果をご自身の目でご確認いただけます。
テスト施工の効果にご納得いただき、そのまま本施工をご成約いただいた企業様に限り、特別割引を適用いたします。
なぜ毎月5社限定なのか? WSPは、専門スタッフが現場ごとの建材や温度、湿度を詳細に分析する「プロ専用技術」です。高い施工品質をお約束するリソースの限界から、当月の規定数に達し次第、受付終了となります。お早めにお申し込みください。
まずは「自社の環境で本当に効果があるのか」をノーリスクでご確認ください。
専門スタッフが訪問し、カビ菌の診断と一部エリアのテスト施工を無料で行います。
お問い合わせ・無料相談はこちら
Company Profile
| 会社名 | 株式会社ウインテック |
|---|---|
| 設立 | 2001年6月 |
| 代表者 | 代表取締役 佐藤 勝 |
| 本社所在地 |
〒349-0134 埼玉県蓮田市駒崎318 TEL: 048-766-9903 / FAX: 048-766-9906 |
| 仙台営業所 |
〒981-0954 宮城県仙台市青葉区川平3-42-15 TEL: 022-303-0755 / FAX: 022-303-0756 |
| 従業員数 | 45名 |
| 事業内容 |
・コンクリート床の下地処理工事業 ・コンクリート床の仕上工事業(塗床工事・鏡面仕上げ等) ・WSP(カビ根本分解・防カビ施工)事業 ・建築塗装工事・左官工事 ほか |
| コーポレート サイト |
https://www.win-tech.jp/ |